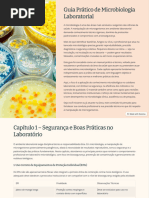

ÁGAR MAC CONKEY
Finalidade:
O ágar MacConkey é um meio diferencial seletivo utilizado para o isolamento e
diferenciação de enterobactérias e uma variedade de outros bastonetes gram-negativos
provenientes de amostras clínicas. Neste meio se pode diferenciar bactérias
fermentadoras da lactose, através da formação de colônias róseas, das bactérias não
fermentadoras da lactose, com formação de colônias incolores.
Registro ANVISA:
10097010-134
Apresentação:
540147 - MAC CONKEY-AGAR-20mL-PL 90X15-PC 10PL
540196 - MAC CONKEY-AGAR-2X10mL-BIPLACA-10PL LB 172067
530106 - MAC CONKEY-AGAR-FR 100mL Rev. 10 – 07/2022
1. INTRODUÇÃO - Sempre considerar as necessidades específicas dos
Atualmente, encontram-se disponíveis muitos meios de cultura para microrganismos alvos das análises, microrganismos com
o isolamento, cultura e identificação de enterobactérias e necessidades especiais (suplementos específicos ou ambiente
microrganismos não fermentadores. Um dos primeiros meios com controlados) podem não apresentar crescimento adequado se
esta capacidade, e ainda com excelente desempenho, a ser semeados em meio de cultura que não apresente os requisitos
desenvolvido foi de autoria de MacConkey, tendo sido publicado em mínimos.
1900 e 1905. Esta formulação foi concebida sabendo-se que os sais
biliares são precipitados por ácidos e que determinados b- Precauções e cuidados especiais
microrganismos entéricos fermentam a lactose ao passo que outros - Produto destinado ao uso diagnóstico in vitro;
não têm esta capacidade. Mais tarde, este meio foi modificado - Não usar materiais com o prazo de validade expirado, ou que
várias vezes. apresentem selo de qualidade rompido ou violado.
Este meio é recomendado para utilização com amostras clínicas - Antes de descartar o material usado, autoclavar a 121ºC por 20
com probabilidade de conter microbiota mista como, por exemplo, a minutos. Para acondicionamento do material usado, recomendamos
urina, fezes, vias respiratórias, feridas, secreções e outras fontes, o uso do Detrilab.
por permitir um agrupamento preliminar de bactérias entéricas e
outras bactérias gram-negativas fermentadoras e não
fermentadoras da lactose, com o objetivo de isolar bactérias gram- 4. INFORMAÇÕES GERAIS SOBRE O PRODUTO
negativas. a- Princípio
Bactérias gram-negativas geralmente se desenvolvem bem neste A diferenciação de bacilos gram negativos fermentadores de lactose
meio e se diferenciam por sua habilidade em fermentar lactose. ocorre pela liberação de íons H+ no meio, que diminui o pH,
Linhagens fermentadoras de lactose crescem como colônias alterando a cor do indicador para rosa, portamo as colônias lacotose
vermelhas ou rosadas e podem ser circundadas por uma área de positiva se mostram com coloração rosa e as colônias lactose
precipitação ácida de bile. A cor vermelha é devida à produção de negativa incolores. A presença do cristal violeta e de sais biliares
ácido pela degradação da lactose, absorção do vermelho neutro e inibem o crescimento dos cocos gram positivos, bem como a
uma subsequente mudança na coloração quando o pH do meio cai formação do swarming das espécies de Proteus.
abaixo de 6,8. Linhagens não-fermentadoras de lactose, como
Shigella spp. e Salmonella spp., são incolores, transparentes e b- Armazenamento e estabilidade
tipicamente não alteram a aparência do meio. Para fins de transporte, o produto pode permanecer em temperatura
ambiente por até 72h. No laboratório as placas devem ser
armazenadas em temperatura de 2 a 25ºC, condições em que se
2. COMPOSIÇÃO mantém estáveis até a data de vencimento expressa em rótulo,
desde que isento de contaminação de qualquer natureza. O uso de
Formulação Concentração/L refrigerador tipo frost-free não é recomendado para meios de cultura
Hidrolisado pancreático de gelatina 17.0 devido ao efeito desidratante deste tipo de equipamento.
Hidrolisado péptico de tecido animal 1.5
Hidrolisado pancreático de caseína 1.5 Considerando que este produto é gelatinoso e sua composição
Lactose 10.0 pode apresentar até 80% de água, ao sofrer variações de
Sais Biliares 1.5 temperatura (quente-frio ou frio-quente) todo meio de cultura pode
Cloreto de sódio 5.0 gerar condensação, de pouca a muita, acumulando água na placa.
Ágar Base 15.0 Recomenda-se guardar as placas com os meios de cultura virados
Cristal violeta 0.001
para cima e, quando necessário, desprezar a água acumulada e
Água deionizada 1L
deixar o meio de cultura estabilizar a temperatura antes de sua
pH 7,1 ±0,2 a 25ºC
utilização.
Conforme descrito em literatura, o laboratório deve retirar da
A formulação pode ser ajustada e/ou suplementada conforme refrigeração apenas a quantidade de produto que deverá ser
necessário para cumprir os critérios do desempenho do produto. utilizada em sua rotina e deixar estabilizar a temperatura, ou secar a
água condensada, antes de sua utilização, em temperatura
ambiente, podendo utilizar a incubação em estufa (± 37ºC) para
3. AMOSTRA redução do tempo de secagem ou estabilização. A repetição do
a- Tipos de amostras processo de refrigeração/estabilização não é recomendada, a
- Podem ser utilizadas amostras clínicas como: urina, fezes, constante troca de temperatura pode levar a desidratação do meio,
secreções e outros fluidos corpóreos, materiais biológicos diversos, expor o produto a contaminações ou gerar um acúmulo de água
amostras ambientais ou quaisquer outras amostras passíveis de excessivo.
conter os microrganismos com capacidade de se desenvolver neste A água acumulada por condensação, ocasionada por alguma
produto. variação de temperatura, não influência no desempenho do produto,
- O laboratório deve estabelecer critérios de coleta, rejeição e desde que este não apresente ressecamento ou diminuição de
conservação das amostras, conforme sua política da qualidade. espessura.
01
www.laborclin.com.br
� LB 172067
ÁGAR MAC CONKEY
Rev. 10 – 07/2022
Devido a presença de substratos sensíveis, recomenda-se manter o 7. RESULTADOS
produto protegido de incidência direta de luz (natural ou artificial) e Relatório
evitar grandes variações de temperatura até a utilização. Relatório
- Não houve crescimento:
d- Precauções e cuidados especiais “Ausência de crescimento microbiano na amostra analisada após
- O produto destinado apenas para o uso diagnóstico in vitro; 24/48h de incubação a 35ºC”;
- Uso restrito por profissionais; - Havendo crescimento:
- Mesmo se tratando de produto livre de agentes infecciosos, “Nome do microrganismo (indicar bactéria identificada)
recomenda-se tratar este produto como potencialmente infeccioso, Contagem de colônias (indicar resultado) UFC/mL“. (apenas quando
observando o uso de equipamentos de proteção individual e aplicável).
coletivo;
- Não inalar ou ingerir; Morfologias típicas das colônias em ágar MacConkey:
- Não utilizar placas com sinais de contaminação, ressecamento ou Microrganismo Características
com alterações de cor ou espessura; Colônias cor-de-rosa a vermelhas (podem
- Não usar materiais com o prazo de validade expirado, ou que estar cercadas por uma zona de
Escherichia coli
apresentem selo de qualidade rompido ou violado; precipitação biliar), dimensão média a
grande.
- Recomenda-se a leitura da diretriz aprovada para “Proteção de
Enterobacter spp., Colônias mucóide, cor-de-rosa, dimensão
Trabalhadores de Laboratório e Infecções Obtidas no Trabalho - Klebsiella spp. grande.
CLSI® M29-A” para o manuseio seguro; Proteus ssp., Colônias incolores, de dimensão grande.
- O procedimento de descarte do produto se baseia na RDC 222 Morganella spp., Providencia A proliferação em torno das colônias
(ANVISA) de 28 de março de 2018, que regulamenta as boas spp. isoladas é inibida (swarming).
práticas de gerenciamento dos resíduos de serviços de saúde. Salmonella spp.,
Colônias incolores. Cor do meio: cor-de-
- Para acondicionamento do material a ser autoclavado, laranja a âmbar, devido a redução de pH
Shigella spp.
recomendamos o uso dos sacos para autoclavação - Detrilab. no meio. Dimensão média a grande.
Colónias irregulares, incolores a cor-de-
- Contate o serviço de vigilância sanitária de sua região para Pseudomonas spp.
rosa, dimensão variável.
garantir o cumprimento correto da legislação de descarte de Cocos gram positivos Inibição parcial a total.
produtos potencialmente contaminantes. Fungos e Leveduras Inibição parcial a total.
Os bacilos gram negativos são identificados inicialmente com base
5. MATERIAIS E EQUIPAMENTOS NECESSÁRIOS (porém não na fermentação ou não da glicose. Na rotina laboratorial a
fornecidos) diferenciação inicial pode utilizar características da colônia para
- Estufa bacteriológica; decisão do processo de identificação, juntamente com o teste de
- Alças bacteriológicas; oxidase. A utilização do Sistema Bactray, kit de Enterobactérias ou
- Bico de Bunsen; provas bioquímicas (TSI, LIA, SIM, MIO, entre outras) é necessária
- Placas de Petri estéreis (para uso com o frasco de 100 mL); para a conclusão da identificação do microrganismo.
- Banho-Maria (para uso com o frasco de 100 mL).
8. LIMITAÇÕES DO MÉTODO
6. PROCEDIMENTO TÉCNICO (Riscos Residuais Identificados conforme RDC 35/2015)
Placas prontas para uso: - A utilização de corantes na formulação pode acarretar leve foto
a- Retirar o pacote da refrigeração e, em ambiente asséptico, sensibilidade, recomenda-se proteger o produto da incidência direta
separar as placas a serem usadas, devolvendo o restante ao da luz.
refrigerador; - Meios de cultura apresentam grande quantidade de água em sua
b- Colocar as placas em estufa bacteriológica entre 35-37ºC pelo formulação, deste modo, variações de temperatura devem
tempo necessário para adquirirem esta temperatura, ou deixar ocasionar a condensação e, consequentemente, o acúmulo de água
estabilizar/secar em temperatura ambiente; na placa. O cuidado com o acondicionamento e exposição do meio
c- Usando procedimentos adequados, proceder a inoculação do a estas variações de temperatura são fundamentais para a
material diretamente na superfície do meio; manutenção da qualidade do produto.
d- Incubar o material em estufa bacteriológica entre 35-37°C por 18- - Algumas variações de coloração na colônia, morfologia ou
24h; tamanho podem ocorrer, devido a características únicas da cepa
e- Após a incubação, avaliar o padrão de crescimento, aspectos analisada.
morfológicos e a fermentação ou não da lactose; - A presença de mais de uma variante genética intrínseca a cepa
f- Devido a exigências especiais, alguns microrganismos podem analisada, pode interferir nas características de crescimento. É
necessitar de um período maior de incubação, se não ocorrer o possível que características únicas ou mutadas da cepa possam
crescimento nas primeiras 24 horas, ou caso o crescimento interferir no desempenho do meio de cultura afetando ou retardando
apresentado não seja o suficiente, incubar o material em estufa o total desenvolvimento das colônias.
bacteriológica entre 35-37ºC, por mais18-24h; - Inóculos com excesso de carga bacteriana podem interferir na
g- Após o total desenvolvimento das colônias, proceder com os avaliação de resultados.
processos de identificação conforme estabelecido em seu - A presença de mais de um microrganismo na amostra pode
laboratório; ocasionar sobreposição de colônias na superfície do meio de
h- A avaliação microscópica de colorações de Gram da amostra e, cultura, dificultando sua identificação, para estes casos, recomenda-
se necessário, da colônia analisada pode elucidar dúvidas e se o reisolamento das colônias diferentes, mantendo a contagem da
oferecer um melhor direcionamento para o processo de placa inicial.
identificação. - Para assegurar a qualidade do desenvolvimento das colônias de
enterobactérias neste meio de cultura, os volumes de inibidores são
Meio em frascos com 100 mL: controlados, o que pode ocasionar, embora muito raramente, o
a- Levar o frasco ao banho-maria fervente até obter a liquefação do crescimento de estirpes de enterococos ou de estafilococos. Estas
meio (sem ferver o meio); cepas, normalmente, apresentam características mutadas e
b- Distribuir de forma asséptica todo o conteúdo do frasco nas resistência aumentada a ação de sais biliares e cristal violeta. Para
placas de Petri estéreis (20 mL por placa 90x15 mm diâmetro); estes casos, sugere-se o reisolamento das colônias em meios
c- Submeter as placas ao controle de esterilidade e qualidade; nutritivos.
d- As placas após preparadas terão sua validade estabelecida pelo - A qualidade dos resultados de análises microbiológicas é
usuário, e podem ser usadas conforme procedimento descrito no intimamente ligada à qualidade da amostra, as melhores práticas
item “Placas prontas para uso”. pré-analíticas, como cuidados extremos com a assepsia do
processo ou paciente, garantem um melhor resultado.
02
www.laborclin.com.br
� LB 172067
ÁGAR MAC CONKEY
Rev. 10 – 07/2022
- Alguns microrganismos fastidiosos, gram-negativos ou não, não 411/4411 100,0% 485/485 100,0%
apresentam crescimento neste meio de cultura (Neisseria Escherichia coli
(99,6 – 100%) (99,8 – 100%)
gonorrhoeae, Mycobacterium spp., Legionella spp., Bordetella spp.
por exemplo). Para a recuperação destas espécies, utilizar meios de 304/304 100,0% 701/701 100% (98,2
Proteus mirabilis
cultura apropriados. (99,3 – 100%) – 100%)
- Embora as características das colônias sugiram a possibilidade de
212/213 99,6% (97,9 307/307 100%
serem realizados alguns testes de diagnóstico diretamente neste Klebsiella pneumoniae
– 99,9%) (99,1 – 100%)
meio de cultura, é indispensável à realização de testes bioquímicos
para uma completa identificação e, se indicado, a realização de 10. GARANTIA DA QUALIDADE
testes imunológicos usando culturas puras. Consultar a bibliografia A Laborclin obedece ao disposto na Lei 8.078/90 - Código de
apropriada para mais informações. Defesa do Consumidor. Para que o produto apresente seu melhor
desempenho, é necessário:
- Os resultados falso–negativos podem ocorrer, com maior - que o usuário conheça e siga rigorosamente o presente
frequência, nas seguintes situações: procedimento técnico;
Técnica de coleta inadequada - que os materiais estejam sendo armazenados nas condições
Incubação em temperatura inadequada indicadas;
Uso de antimicrobiano prévio - que os equipamentos e demais acessórios necessários estejam
Utilização de alça flambada não resfriada em boas condições de uso, manutenção e limpeza.
Tempo de incubação insuficiente Antes de ser liberado para venda, cada lote do produto é submetido
Infecção crônica (infecção pouco ativa) a testes específicos, que são repetidos periodicamente conforme
Armazenamento ou transporte de amostra inadequado calendário estabelecido pela empresa até a data de vencimento
Agentes etiológicos exigentes com relação aos meios de expressa em rótulo. Os certificados de análise de cada lote podem
cultura ser obtidos no site www.laborclin.com.br. Em caso de dúvidas ou
quaisquer problemas de origem técnica, entrar em contato com o
Necessidade de meios especiais para o crescimento de
SAC - Serviço de Assessoria ao Cliente através do telefone 0800-
um agente infeccioso específico
0410027 ou pelo e-mail sac@laborclin.com.br. Quaisquer problemas
que inviabilizem uma boa resposta do produto, que tenham ocorrido
- Os resultados falso–positivos podem ocorrer, com maior
comprovadamente por falha da Laborclin serão resolvidos sem ônus
frequência, nas seguintes situações:
ao cliente, conforme o disposto em lei.
Técnica de assepsia inadequada
Erro na conservação do material
Tempo longo entre a coleta e análise 11. REFERÊNCIAS
Tempo excessivo de incubação 1. Association of Official Analytical Chemists. 1995. Bacteriological
Interpretação equivocada de colônias não patogênicas analytical manual, 8th ed., App. 3.08-3.09. AOAC International,
Utilização de material vencido, contaminado ou em Gaithersburg, MD.
condições inadequadas 2. Baron, E.J., L.R. Peterson, and S.M. Finegold. 1994. Bailey &
Contaminação cruzada por uso de acessórios não Scott's diagnostic microbiology, 9th ed. Mosby-Year Book, Inc., St.
esterilizados corretamente ou ambiente não asséptico Louis.
3. Baron, E. J, L. R. Peterson, and S. M. Finegold. 1994. Bailey &
Scott’s diagnostic microbiology, 9th ed., p. 415. Mosby-Year Book,
9. CONTROLE DA QUALIDADE Inc. St. Louis, MO.
- Materiais necessários 4. Chapin, K.C., and T.-L Lauderdale. 2003. Reagents, stains, and
Cepas padrão: ATCC® (American Type Culture Collection) ou media: bacteriology. In: Murray, P. R., E. J. Baron, J.H. Jorgensen,
derivadas). M. A. Pfaller, and R. H. Yolken (ed.). Manual of clinical microbiology,
8th ed. American Society for Microbiology, Washington, D.C.
- Controle de qualidade recomendado: 5. Difco Manual, 2º ed., 2009.
Cepas Resultado esperado 6. Downes, F.P., and K. Ito. 2001. Compendium of methods for the
Escherichia coli Crescimento bom – Lactose microbiological examination of foods. 4th edition. American Public
ATCC 25922 positiva Health Association (APHA). Washington, D.C. USA.
Proteus mirabilis Crescimento bom – Lactose 7 Dunne Jr. W.M., Nolte, F.S. and Wilson, M.L. Blood Culture III.
ATCC 25933 negativa CUMITECH 1B. Coord. Ed. J.A. Hindler, American Society for
Staphylococcus aureus Microbiology, Washington, DC, 1997.
Inibição total
ATCC 25923
8 Ellner, P.D., C.J. Stoessel, E. Drakeford, and F. Vasi. 1966. A new
Meio sólido, levemente opaco,
com coloração salmão a
culture medium for medical bacteriology. Am. J. Clin. Pathol. 45:
Meio não inoculado avermelhada, podendo 502-504.
apresentar pequenos 9 Farmer III, J.J. 2003. Enterobacteriaceae: introduction and
precipitados. identification. In: Murray, P. R., E. J. Baron, J.H. Jorgensen, M. A.
Pfaller, and R. H. Yolken (ed.). Manual of clinical microbiology, 8th
- Periodicidade ed. American Society for Microbiology, Washington, D.C.
Testar a cada novo lote recebido ou em periodicidade estabelecida 10 Isenberg, H. D. (ed.). 1992. Interpretation of aerobic bacterial
pelo próprio laboratório. growth on primary culture media, Clinical microbiology procedures
handbook, vol.1, p. 1.6.1-1.6.7. American Society for Microbiology,
- Análise dos resultados Washington, D.C.
As cepas inoculadas no material devem apresentar características 11. Jacobs, J.A., De Brauwer, E.I.G.B., Cornelissen, E.I.M. and
de crescimento esperados. Caso se constate algum problema ou Drent, M. Accuracy and precision of quantitative calibrated loops in
diferença, os resultados de amostras clínicas não devem ser transfer of bronchoalveolar lavage fluid. J Clin Microbiol 38(6):2117-
liberados até que as causas tenham sido apuradas devidamente e 2121, 2000.
os problemas constatados sanados. 12. Koneman, Elmer; et al. Diagnostic Microbiology. Lippincott, USA,
6 ed., 2010.
- Este produto apresenta sensibilidade e especificidade ≥ 99,6% 13. Levine, M., and H.W. Schoenlein. 1930. A compilation of culture
frente aos principais microrganismos não fastidiosos. media for the cultivation of microorganisms. The Williams & Wilkins
Company, Baltimore.
Sensibilidade % Especificidade % 14. MacConkey, A. 1905. Lactose-fermenting bacteria in faeces. J.
Microrganismo (Intervalo de (Intervalo de Hyg. 5:333-379.
confiança de 95%) confiança de 95%)
03
www.laborclin.com.br
� LB 172067
ÁGAR MAC CONKEY
Rev. 10 – 07/2022
15. MacConkey, A.T. 1900. Note on a new medium for the growth
and differentiation of the Bacillus coli communis and the Bacillus
typhi abdominalis. The Lancet, Part II:20.
16. MacFaddin, J.F. 1985. Media for isolation-cultivation-
identification-maintenance of medical bacteria, vol. I. Williams &
Wilkins, Baltimore.
17. Mahon, Connie, Manuselis, George Jr. Diagnostic Microbiology.
Saunders, USA, 1995.
18. Manual of clinical microbiology, 8th ed. American Society for Laborclin Produtos para Laboratórios Ltda
Microbiology, Washington, D.C. CNPJ 76.619.113/0001-31
19. Mazura-Reetz, G., T.R. Neblett, and J.M. Galperin. 1979. Insc. Estadual 1370012926
MacConkey agar: CO2 vs. ambient incubation, abstr. C 179, p. 339. Rua Casimiro de Abreu, 521
Pinhais/PR CEP 83.321-210
Abstr. 79th Annu. Meet. Am. Soc. Microbiol. 1979.
Telefone 041 36619000
20. Murray, P. R., E. J. Baron, J.H. Jorgensen, M. A. Pfaller, and R. www.laborclin.com.br
H. Yolken (ed.). 2003. Manual of clinical microbiology, 8th ed. Responsável Técnico:
American Society for Microbiology, Washington, D.C. Daniela Fialho – CRF/PR-37492
21. Murray, P.R. et al. Manual of Clinical Microbiology. 7th ed, Serviço de Assessoria ao Cliente
American Society for Microbiology 1999. SAC 0800-0410027
22. NNIS. National Nosocomial Infections Surveillance. MMWR, 49, sac@laborclin.com.br
8, March 3, 2000.
23. Reller, R.B., Murray, P.R. and MacLowry, J.D. Blood Culture II.
CUMITECH 1A. Coord. Ed. J.A. Washington II, American Society for
Microbiology, Washington, DC, 1982.
24. Silva, de Neusely; et al. Manual de Métodos de Análise
Microbiológica de Alimentos e Água, 4° ed., 2010.
25. Schryver, A. and Meheus, A. Epidemiology of sexually
transmitted diseases: a global picture. Bull WHO, 68:639–654, 1990.
26. Thomson, R.B., and J.M. Miller. 2003. Specimen collection,
transport, and processing: bacteriology. In: Murray, P. R., E. J.
Baron, J.H. Jorgensen, M. A. Pfaller, and R. H. Yolken (ed.).
04
www.laborclin.com.br
� LB 172067
ÁGAR MAC CONKEY
Rev. 10 – 07/2022
ANEXO 1 – LISTA DE SÍMBOLOS UTILIZADOS NOS RÓTULOS
Fonte: ABNT NBR ISO 15223-1 – Segunda edição (28.07.2015)
05
www.laborclin.com.br